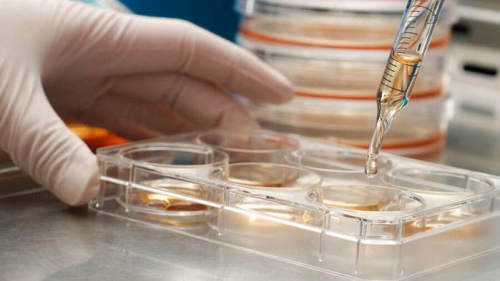

Процедура экстракорпорального оплодотворения (ЭКО) становится популярным методом решения бесплодия. Многие пары, желающие стать родителями, обращаются к этому способу. В статье мы подробно рассмотрим каждый этап ЭКО, разбив процесс на дни, чтобы вы могли понять, чего ожидать. Эта информация будет полезна как для новичков, так и для тех, кто хочет освежить свои знания о процедуре.
Контролируемая стимуляция яичников
Женщина проходит курс лечения с использованием определенных гормональных препаратов, преследуя две главные цели:
-
Стимулировать одновременное созревание нескольких яйцеклеток в одном менструальном цикле, в отличие от естественного процесса, при котором созревает только одна яйцеклетка.
-
Активировать яичники для планирования овуляции, что значительно повышает шансы на успешное зачатие.
Существует несколько медицинских протоколов для стимуляции яичников, которые в основном включают использование гонадотропинов и аналогов гонадолиберина. Эндокринолог-репродуктолог, учитывая индивидуальные особенности каждой женщины и ее клиническую ситуацию, выбирает наиболее подходящий вариант.
Процесс стимуляции яичников обычно длится от 6 до 14 дней. В этот период с помощью ультразвукового исследования контролируют развитие фолликулов, измеряют толщину эндометрия и определяют оптимальный день для забора яйцеклеток. Также проводится оценка уровня эстрадиола в крови.
Препараты для стимуляции:
• ФСГ (фолликулостимулирующий гормон гипофиза). ФСГ способствует росту и созреванию фолликулов. В настоящее время чаще всего используется Пурегон — гормональный препарат с высоким уровнем безопасности.
• Аналоги гонадолиберина. Их основная функция заключается в блокировке выработки гипофизом собственных гормонов, которые могут препятствовать проведению суперстимуляции. Наиболее эффективным препаратом является Оргалутран, который обеспечивает мгновенную блокировку гипофиза, в отличие от ранее применяемых средств, требующих длительного приема в течение месяца.
• Хорионический гонадотропин. ХГЧ играет важную роль в созревании фолликулов. Препарат Прегнил назначается непосредственно перед проведением пункции.
Процедура ЭКО включает несколько ключевых этапов, каждый из которых требует внимательного подхода и профессионализма. Врачи подчеркивают, что первым шагом является стимуляция яичников с помощью гормональных препаратов, что позволяет получить несколько яйцеклеток вместо одной. После этого проводится мониторинг роста фолликулов с помощью УЗИ и анализов крови. Когда фолликулы достигают нужного размера, назначается инъекция для их созревания.
Следующий этап — пункция яичников, которая осуществляется под контролем УЗИ. Врач извлекает яйцеклетки, после чего они помещаются в специальную среду для оплодотворения. Важно отметить, что оплодотворение может происходить как классическим методом, так и с использованием ИКСИ, когда сперматозоид вводится непосредственно в яйцеклетку.
После оплодотворения эмбрионы культивируются в лаборатории, и через несколько дней выбираются наиболее жизнеспособные для переноса в матку. Врачи акцентируют внимание на том, что успешность процедуры зависит от множества факторов, включая возраст женщины и качество эмбрионов. На финальном этапе проводится перенос эмбриона, и пациентка ожидает результатов теста на беременность. Весь процесс требует высокой квалификации специалистов и тщательного наблюдения за состоянием здоровья женщины.
https://youtube.com/watch?v=0L9kYAFQp3A
Сбор яйцеклеток
Извлечение яйцеклеток производится посредством пункции фолликулов, что оправдано только при условии достижения ооцитами достаточной зрелости (метафаза II). Важно предотвратить их самопроизвольный выход, то есть естественную овуляцию. Обычно процедуру извлечения ооцитов назначают через 34-40 часов после введения ХГЧ.
Манипуляция проводится под наркозом с использованием ультразвукового контроля. Фолликулы, представляющие собой мешочки с яйцеклетками, прокалываются специальной иглой, и содержимое аспирируется в пробирку. Затем полученный материал анализируется на пригодность в лабораторных условиях. Вся процедура занимает около 30 минут.
| Этап ЭКО | Описание этапа | Цель этапа |
|---|---|---|
| 1. Стимуляция суперовуляции | Прием гормональных препаратов для стимуляции яичников к выработке нескольких зрелых яйцеклеток. | Получение достаточного количества яйцеклеток для оплодотворения. |
| 2. Мониторинг роста фолликулов | Регулярные УЗИ-исследования и анализы крови для отслеживания роста фолликулов и уровня гормонов. | Определение оптимального времени для забора яйцеклеток. |
| 3. Пункция фолликулов (забор яйцеклеток) | Трансвагинальная аспирация фолликулов под контролем УЗИ для извлечения яйцеклеток. Проводится под наркозом. | Получение зрелых яйцеклеток для оплодотворения. |
| 4. Получение спермы | Сбор спермы у партнера (или использование донорской спермы). | Получение сперматозоидов для оплодотворения яйцеклеток. |
| 5. Оплодотворение (инсеминация или ИКСИ) | Соединение яйцеклеток и сперматозоидов в лабораторных условиях. Может быть стандартное оплодотворение (инсеминация) или интрацитоплазматическая инъекция сперматозоида (ИКСИ). | Создание эмбрионов. |
| 6. Культивирование эмбрионов | Выращивание эмбрионов в специальной среде в инкубаторе в течение 3-5 дней. | Развитие эмбрионов до стадии, пригодной для переноса. |
| 7. Перенос эмбрионов | Введение одного или нескольких эмбрионов в полость матки с помощью тонкого катетера. | Имплантация эмбрионов в стенку матки для наступления беременности. |
| 8. Поддержка лютеиновой фазы | Прием гормональных препаратов (прогестерона) для поддержания слизистой оболочки матки и создания благоприятных условий для имплантации. | Поддержание беременности на ранних сроках. |
| 9. Тест на беременность | Анализ крови на ХГЧ через 10-14 дней после переноса эмбрионов. | Подтверждение наступления беременности. |
Сбор и подготовка спермы
Образец спермы получают с помощью мастурбации. Основная задача лабораторных исследований заключается в получении высококачественных зрелых сперматозоидов и удалении дефектных форм, имеющих патологии, такие как проблемы с хвостом, головкой или двигательной активностью. В естественных условиях после семяизвержения мужские половые клетки взаимодействуют с женской репродуктивной системой, что позволяет им перейти на завершающую стадию развития и приобрести способность к оплодотворению.
По мере движения к фаллопиевым трубам, где располагается яйцеклетка, сперматозоиды претерпевают ряд изменений: они получают возможность проникать в zona pellucida яйцеклетки благодаря акросомальной реакции (высвобождению ферментов, разрушающих оболочку ооцита) и изменяют свою траекторию движения. При экстракорпоральном оплодотворении (ЭКО) этот процесс имитируется, чтобы сперматозоиды смогли обрести оплодотворяющую способность. Перед обработкой эякулята необходимо подождать 30 минут для его разжижения, после чего начинается этап отмывки, во время которого удаляется семенная плазма, которая иногда может быть токсичной для половых клеток как мужчин, так и женщин.
В сперме могут присутствовать патогенные микроорганизмы, способные вызвать воспалительные процессы. Семенная плазма содержит простагландины, которые способствуют сокращению миометрия и могут препятствовать имплантации. Репродуктологи стремятся увеличить долю нормальных половых клеток с правильной подвижностью. В последние годы в рамках вспомогательных репродуктивных технологий начали использовать отбор сперматозоидов с определенными генетическими характеристиками, что особенно важно при наследственных заболеваниях, связанных с Х или У-хромосомой. Это позволяет получить здорового ребенка определенного пола. Существует несколько методов обработки спермы:
• фильтрация;
• флотация (всплытие наиболее качественных клеток на поверхность питательной среды);
• центрифугирование в градиенте плотности;
• проточная цитометрия.
Сначала проводят центрифугирование после разжижения, а затем применяют один из перечисленных методов.
Если мужчина не может предоставить образец спермы через мастурбацию, возможны другие варианты, такие как биопсия яичка или микрохирургическая аспирация сперматозоидов из эпидидимиса (MESA). Эти процедуры используются для ЭКО с применением ИКСИ в случаях недостаточного количества сперматозоидов или их низкого качества.
https://youtube.com/watch?v=yQScsPWKM_M
Оплодотворение яйцеклетки
Данный этап подразумевает соединение яйцеклетки и сперматозоида для достижения объединения ДНК от обоих родителей. Уровень участия эмбриолога в этом процессе может различаться в зависимости от конкретной ситуации.
Классическое ЭКО
Эмбриолог выполняет важную задачу, заключающуюся в том, чтобы разместить биоматериал от мужчины и женщины в чашке Петри для дальнейшего культивирования. Предполагается, что сперматозоиды могут самостоятельно достигать яйцеклеток.
https://youtube.com/watch?v=73WwCJ7bmzQ
ИКСИ
Эмбриолог вручную вводит сперматозоид в яйцеклетку, используя микроскоп для контроля процесса.
Спустя 16-20 часов проводится проверка на предмет успешного оплодотворения яйцеклетки, или, к сожалению, выявляется, что произошла ошибка, приведшая к неудаче.
Культивация эмбрионов
Оплодотворенные яйцеклетки помещаются в специальную культуральную среду, что способствует их дальнейшему развитию. На протяжении этого времени они проходят этапы роста от зиготы до эмбриона, а затем превращаются в бластоцисту. Инкубатор, предназначенный для этих целей, создает оптимальные газовые и температурные условия, необходимые для эмбрионального развития вплоть до момента переноса. Эмбриологи внимательно наблюдают за процессом, чтобы оценить качество эмбрионов.
Подготовка эндометрия
В дополнение к медикаментам, применяемым для лечения бесплодия и стимуляции яичников, женщины, проходящие процедуру ЭКО, также получают гормональные средства для подготовки эндометрия. Основная задача этих препаратов — повысить восприимчивость эндометрия, что, в свою очередь, увеличивает вероятность успешной имплантации эмбрионов.
В нормальных условиях толщина эндометрия составляет примерно от 7 до 10 мм, что создает оптимальные условия для прикрепления эмбриона.
Для достижения этой цели обычно назначаются эстрогены и прогестерон, которые могут вводиться различными способами: перорально, вагинально или трансдермально (через кожу).
Перенос эмбрионов
Репродуктолог выбирает наиболее перспективный эмбрион с высоким потенциалом для имплантации, который переносится в матку матери на 5-7 день после овуляции с использованием специального катетера. Успешное прикрепление эмбриона приведет к наступлению беременности.
Этапы переноса при ЭКО:
• Во влагалище вводятся стерильные зеркала, после чего оно очищается физиологическим раствором.
• Шейка матки обрабатывается питательной средой, и производится аспирация шеечной слизи.
• Отобранные эмбрионы помещаются в специальную полую трубку.
• Катетер вводится через шейку матки вагинально.
• Эмбрионы аккуратно помещаются в матку.
• Катетер медленно и осторожно извлекается из влагалища.
Процедура занимает всего несколько минут и не требует анестезии или седации. Женщина может почувствовать небольшой дискомфорт, однако в целом это безболезненная манипуляция.
Существует два основных варианта переноса эмбрионов:
• Естественный цикл. Процесс проходит без применения медикаментов или с минимальным использованием прогестерона. Циклы ЭКО и ИКСИ редко проводятся без прогестерона.
• Стимулированный цикл. В этом случае назначаются гормональные препараты, такие как эстроген и прогестерон, для подготовки эндометрия.
Специалисты индивидуально определяют день переноса эмбрионов, учитывая такие факторы, как количество доступных эмбрионов, их качество, восприимчивость эндометрия и результаты предыдущих циклов, если они имелись.
Перенос может быть выполнен на любой стадии развития эмбриона. Некоторые клиники осуществляют его на стадии зиготы, другие выбирают 2-й день или стадию морулы. Однако наиболее распространенной практикой является перенос на 3-й день (ранняя стадия деления) или на 5-й день, когда эмбрион достигает стадии бластоцисты. У каждого из этих этапов есть свои плюсы и минусы.
В зависимости от того, используются ли замороженные или свежие эмбрионы, выделяют два типа переноса:
• Подсадка свежего эмбриона. Эмбрионы переносятся в том же цикле, без предварительного замораживания.
• Пересадка замороженного эмбриона. Эмбрионы могут быть криоконсервированы для последующего переноса в рамках других протоколов ЭКО.
Этот метод оправдан, если эмбрионы не могут быть перенесены в одном цикле, например, при развитии синдрома гиперстимуляции яичников у женщины.
Перенос при ЭКО может быть отменен в случае отсутствия эмбрионов, если полученный эмбрион не подходит для имплантации или может привести к рождению неполноценного ребенка. Причины для отказа от переноса включают:
• Ошибку оплодотворения. Ооцит не оплодотворяется, и, соответственно, эмбрионы не образуются.
• Эмбриональные дефекты. Генетические отклонения или аномалии в развитии эмбриона (чаще всего наблюдаются на стадии бластоцисты) делают беременность с таким биоматериалом нежелательной или невозможной. В таких случаях цикл ЭКО необходимо начинать заново.
• Недоразвитие слизистой оболочки матки. Если слизистая оболочка не готова к принятию эмбрионов, они будут заморожены и перенесены в следующих циклах.
Большинство клиник по лечению бесплодия рекомендуют перенос одного или двух эмбрионов, чтобы снизить риск многоплодной беременности. Определение количества эмбрионов для переноса является сложной задачей и зависит от множества факторов, включая:
• возраст женщины;
• качество эмбрионов;
• состояние эндометрия;
• причины бесплодия;
• эффективность методов криоконсервации.
Все больше специалистов рекомендуют перенос одного эмбриона, чтобы минимизировать риск многоплодной беременности, которая может представлять опасность как для матери, так и для детей.
Какова судьба неиспользованных эмбрионов
Для переноса выбираются только те эмбрионы, которые соответствуют оптимальным критериям. Однако могут остаться неиспользованными зародыши высокого качества, которые в таком случае могут быть подвергнуты криоконсервации (замораживанию) на неопределенный срок. Это позволяет использовать биоматериал в будущих циклах ЭКО.
Если беременность наступила, и женщина планирует в дальнейшем иметь больше детей, криоконсервированные эмбрионы могут быть применены в новом протоколе ЭКО. Главное преимущество заключается в том, что ей не придется проходить полный цикл заново; достаточно будет принять препараты для подготовки эндометрия к новому переносу. В этом случае риск осложнений значительно снижается.
Существуют ситуации, когда пациентка или пара не планируют иметь больше детей. В таких случаях запасные эмбрионы могут быть переданы другим людям.
Ожидание результатов ЭКО
Тревога, неуверенность и негативные эмоции могут усугубить ваше состояние, поэтому важно научиться расслабляться и не зацикливаться на происходящем. Не стоит проводить тесты на беременность слишком рано (до 12 дня после имплантации). Попробуйте читать книги, смотреть вдохновляющие фильмы и уделять больше времени отдыху. Рекомендуется избегать сексуальной активности и физических нагрузок. Обязательно следуйте указаниям врача и не пропускайте прием назначенных препаратов. Специальных рекомендаций по питанию нет, но ваше меню должно включать достаточное количество белков, жиров и углеводов.
Психологическая поддержка во время процедуры ЭКО
Процедура экстракорпорального оплодотворения (ЭКО) является сложным и многогранным процессом, который требует не только физической, но и психологической подготовки. Психологическая поддержка играет важную роль на всех этапах ЭКО, начиная с подготовки к процедуре и заканчивая периодом ожидания результатов.
Первоначально, когда пара принимает решение о проведении ЭКО, они могут столкнуться с множеством эмоций, включая страх, тревогу и неуверенность. Важно, чтобы на этом этапе пары могли обратиться за консультацией к психологу, который специализируется на репродуктивных технологиях. Психолог может помочь разобраться в чувствах, обсудить страхи и ожидания, а также подготовить к возможным трудностям.
Во время гормональной стимуляции, которая является одним из ключевых этапов ЭКО, женщины могут испытывать физические и эмоциональные изменения. Гормональные препараты могут вызывать перепады настроения, раздражительность и даже депрессию. Психологическая поддержка в этот период может включать в себя техники релаксации, медитации и другие методы, помогающие справиться с эмоциональными нагрузками.
Кроме того, важно, чтобы партнеры поддерживали друг друга. Открытое общение о переживаниях и чувствах может значительно укрепить отношения и помочь справиться с эмоциональными трудностями. Пары могут также рассмотреть возможность участия в группах поддержки, где они смогут поделиться своим опытом с другими, кто проходит через аналогичные испытания.
На этапе переноса эмбрионов, когда происходит одно из самых волнительных событий, психологическая поддержка становится особенно актуальной. Ожидание результатов теста на беременность может быть источником значительного стресса. Психологи рекомендуют использовать техники управления стрессом, такие как дыхательные упражнения и позитивные аффирмации, чтобы снизить уровень тревожности.
Если результат теста оказывается положительным, это может вызвать как радость, так и новые страхи, связанные с беременностью. Психологическая поддержка на этом этапе может помочь справиться с новыми эмоциями и подготовиться к изменениям, которые произойдут в жизни пары. Важно помнить, что каждая пара уникальна, и подход к психологической поддержке должен быть индивидуальным.
В случае, если ЭКО не приводит к желаемому результату, пары могут испытывать глубокое разочарование и горе. Психолог может помочь в процессе горевания, а также в принятии решения о дальнейших действиях, будь то повторная попытка ЭКО, использование донорских клеток или другие варианты. Поддержка в этот период особенно важна, так как она может помочь парам сохранить надежду и найти силы для дальнейших шагов.
Таким образом, психологическая поддержка во время процедуры ЭКО является неотъемлемой частью успешного прохождения всех этапов. Она помогает справиться с эмоциональными трудностями, укрепляет отношения и способствует принятию решений, что в конечном итоге может привести к желаемому результату.
Побочные эффекты и риски процедуры ЭКО
Процедура экстракорпорального оплодотворения (ЭКО) может быть эффективным методом лечения бесплодия, однако, как и любая медицинская процедура, она сопряжена с определенными побочными эффектами и рисками. Важно, чтобы пациенты были осведомлены о возможных последствиях, прежде чем принимать решение о проведении ЭКО.
Одним из наиболее распространенных побочных эффектов является синдром гиперстимуляции яичников (ГСЯ). Этот синдром может возникнуть в результате чрезмерной реакции яичников на гормональную стимуляцию, используемую для увеличения количества яйцеклеток. Симптомы ГСЯ могут варьироваться от легких до тяжелых и включают боли в животе, увеличение живота, тошноту, рвоту и затрудненное дыхание. В редких случаях ГСЯ может привести к серьезным осложнениям, таким как тромбообразование или даже необходимость в госпитализации.
Другим возможным побочным эффектом является эмоциональная нестабильность. Процесс ЭКО может быть эмоционально напряженным, и многие женщины испытывают стресс, тревогу и депрессию в течение всего цикла лечения. Гормональные изменения, вызванные препаратами, также могут усугубить эти состояния. Поддержка со стороны партнеров, друзей и специалистов в области психологии может помочь справиться с эмоциональными трудностями.
Существует также риск многоплодной беременности, особенно если в процессе ЭКО имплантируется несколько эмбрионов. Многоплодная беременность может привести к более высокому риску осложнений как для матери, так и для детей, включая преждевременные роды, низкий вес при рождении и повышенные риски для здоровья новорожденных.
Кроме того, некоторые исследования указывают на возможную связь между ЭКО и повышенным риском определенных заболеваний у детей, таких как пороки развития или генетические аномалии. Однако эти риски остаются предметом обсуждения, и необходимы дополнительные исследования для окончательных выводов.
Наконец, стоит отметить, что процедура ЭКО может быть финансово затратной, и не всегда гарантирует успех. Это может привести к дополнительному стрессу и разочарованию, особенно если попытки забеременеть не увенчиваются успехом. Поэтому важно заранее обсудить все возможные риски и побочные эффекты с врачом, чтобы принять обоснованное решение о проведении процедуры.
Следующие шаги после успешного или неудачного ЭКО
После завершения процедуры экстракорпорального оплодотворения (ЭКО) наступает важный этап, который включает в себя как эмоциональные, так и физические аспекты. В зависимости от результата, шаги, которые необходимо предпринять, могут различаться.
1. Успешное ЭКО
Если тест на беременность показывает положительный результат, это означает, что имплантация эмбриона прошла успешно. В этом случае необходимо:
- Записаться на консультацию к врачу: Важно как можно скорее посетить врача для подтверждения беременности с помощью ультразвукового исследования. Это позволит убедиться в наличии сердцебиения и правильном развитии плода.
- Следовать рекомендациям врача: Врач может назначить дополнительные анализы и обследования, а также дать рекомендации по образу жизни, питанию и физической активности.
- Психологическая поддержка: Беременность после ЭКО может вызывать смешанные чувства. Рекомендуется обратиться к психологу или консультанту, чтобы обсудить свои эмоции и получить поддержку.
- Регулярные проверки: Важно проходить регулярные обследования, чтобы следить за состоянием здоровья матери и плода на протяжении всей беременности.
2. Неудачное ЭКО
Если тест на беременность показывает отрицательный результат, это может быть эмоционально тяжелым опытом. Важно помнить, что неудача не означает, что вы не сможете забеременеть в будущем. В этом случае рекомендуется:
- Обсудить результаты с врачом: Важно понять причины неудачи. Врач может предложить дополнительные обследования, чтобы выявить возможные проблемы, такие как гормональные нарушения или генетические факторы.
- Дать себе время: Эмоциональное восстановление после неудачного ЭКО может занять время. Позвольте себе пережить горечь утраты и не спешите с принятием решения о следующем шаге.
- Рассмотреть альтернативные варианты: После консультации с врачом можно обсудить возможность повторного ЭКО, использования донорских яйцеклеток или спермы, а также другие методы лечения бесплодия.
- Поддержка близких: Общение с друзьями и семьей может помочь справиться с эмоциями. Не стесняйтесь делиться своими переживаниями и искать поддержку.
Вне зависимости от результата, важно помнить, что каждая ситуация уникальна, и подход к ней должен быть индивидуальным. Консультации с медицинскими специалистами и поддержка близких помогут пройти через этот сложный период и принять правильные решения для будущего.